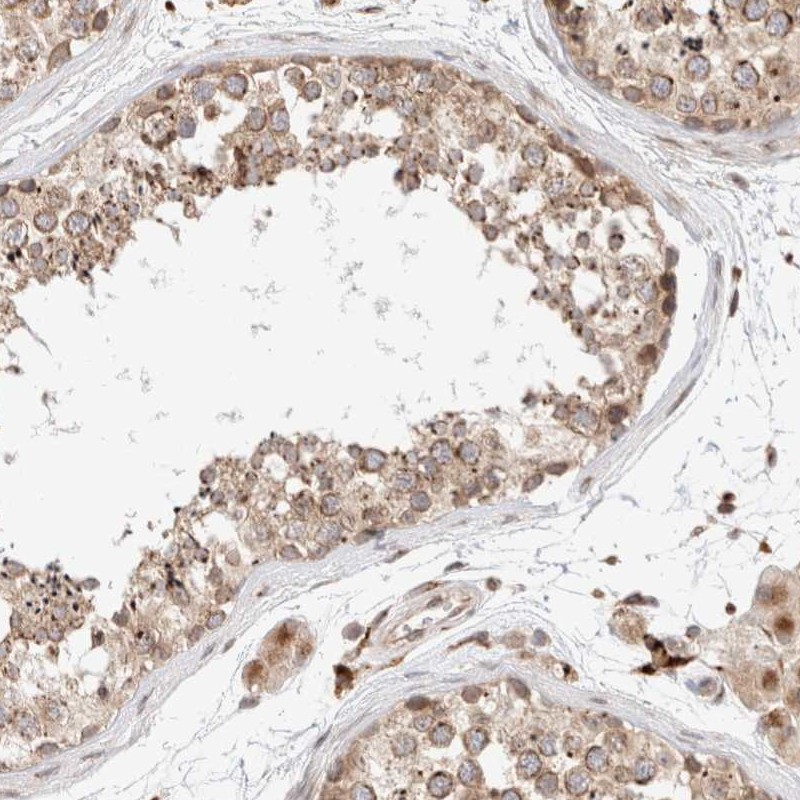

Filter options
Categories
Manufacturer
- ABP Biosciences (87)
- ABclonal (16076)
- ALPCO (53)
- ARP American Research Products (16)
- Abbexa (150156)
- Abbkine Scientific (134)
- Abcepta (98145)
- Abeomics (17378)
- Abnova (70388)
- Absolute Antibody (36693)
- AcroBiosystems (951)
- Active Motif (1658)
- AddexBio (6)
- Affinity Biosciences (16910)
- Agdia EMEA (8)
- Agrisera (2426)
- Alpha Diagnostic (3661)
- AlphaThera (105)
- Ampersand Biosciences (46)
- Anogen-Yes Biotech Laboratories (494)
- Antibodies Incorporated (2261)
- Antibodies.com (113912)
- ApexBio (6389)
- Apop Biosciences (5)
- Aptum Biologics (15)
- Arbor Assays (25)
- Assay Biotechnology (21500)
- Atlas Antibodies (45260)
- Aves Labs (101)
- Aviva (146168)
- BBI Solutions (247)
- BIO SB (3330)
- BMA Biomedicals (785)
- BT Lab (19660)
- Bio X Cell (1720)
- BioActs (64)
- BioAssay Systems (4)
- BioAssay Works (20)
- BioChain Institute (35)
- BioPorto Diagnostics (239)
- BioServUK (71)
- BioTeZ (1)
- BioVendor (187)
- Biogenex (17)
- Biolegend (30046)
- Biomatik Corporation (22101)
- Biomedica (2)
- Biorbyt (1093268)
- Bioss (323664)
- Biosynth (42235)
- Biotium (44957)
- Bioworld Technology (34356)
- BlueGene (103)
- Boster Bio (134722)
- CH3 BioSystems (4)
- Cape Biologix Technologies (57)
- Caprico Biotechnologies (3584)
- Cedarlane (6308)
- Cell Biolabs (12)
- Chondrex (152)
- Chromatrap (23)
- Cloud-Clone (26515)
- Columbia Biosciences (209)
- Concise Separations (114)
- Covalab (9978)
- Creative BioMart (20)
- Creative Biolabs (17130)
- Cusabio (307902)
- Cygnus Technologies (102)
- Cytognos (12)
- Cytoskeleton (42)
- DB-Biotech (483)
- DCS Diagnostics (822)
- DLDEVELOP (16758)
- ELK Biotechnology (11491)
- EXBIO (4567)
- EastCoast Bio (1436)
- Elabscience (19048)
- EnkiLife (20447)
- Enzo Life Sciences (2234)
- Everest (3522)
- FabGennix (4102)
- Fuller (38)
- GeneTex (40655)
- Genesee Scientific (89)
- GenomeMe (534)
- Genscript (852)
- GenuIN Biotechnologies (3624)
- Green Mountain Antibodies (110)
- HUABIO (7283)
- HUMAN (1)
- HansaBioMed (12)
- HelloBio (54)
- Hycult (1452)
- IBA (5)
- ICL (718)
- IHC WORLD (75)
- IQ Products (2)
- ImmuQuest (497)
- ImmunoChemistry Technologies (22)
- ImmunoReagents (1051)
- Immunostep (384)
- Jackson ImmunoResearch (3767)
- Kamiya Biomedical Company (778)
- Kerafast (910)
- Krishgen Biosystems (3)
- Lab-Club (1)
- Lampire Biological Labs (507)
- Leadgene Biomedical (421)
- LifeSpan Biosciences (1004488)
- LifeTein (5)
- Liga Trap Technologies (7)
- Linaris (5346)
- List Biological Labs (2)
- MABTECH (604)
- MBL (2077)
- MP Biomedicals Germany (374)
- MS Validated Antibodies (543)
- MaxVision Biosciences (1)
- MedSchenker (12)
- MedchemExpress (4598)
- Medix Biochemica (883)
- MoBiTec (7)
- Monosan (2469)
- MyBiosource (1562875)
- NABAS (23)
- NSJ Bioreagents (36496)
- NZYtech (4)
- NanoTag Biotechnologies (299)
- Nanoprobes (123)
- NeoBiotechnologies (16438)
- Neuromics (782)
- Nordic BioSite (411054)
- NordicMubio (2696)
- OZ Biosciences (1)
- OncoDianova (14)
- Oxford Biomedical Research (314)
- PBL Assay Science (51)
- Poly-Dtech (25)
- ProSci (36577)
- ProSpec-Tany Technogene (738)
- ProteinArk (5)
- ProteoGenix (20315)
- RD-Biotech (4)
- RayBiotech (52690)
- Reed Biotech (874)
- Reprocell (3)
- RevMAb (447)
- Roboscreen (146)
- Rockland Immunochemicals (9081)
- Sanyou Bio (1034)
- Sceti (2721)
- ScyTek Laboratories (1853)
- Selleck (39)
- SignalChem (32)
- SignalChem Diagnostics (14)
- Sino Biological (204997)
- SouthernBiotech (3473)
- Spherotech (7)
- Statens Serum Institut (321)
- Svar Life Science (5)
- Synabs (1183)
- TOKU-E (11)
- The Native Antigen Company (656)
- Toronto Bioscience (55)
- Trevigen (20)
- U-CyTech biosciences (73)
- UBPBio, LLC (71)
- US Biological (378354)
- VITRO (2071)
- VMRD (60)
- Vazyme Biotech (5)
- Vector Laboratories (89)
- ViroStat (1253)
- Virusys (91)
- Zymo Research Europe (11)
- Zytomed Systems (6808)
- dianova (1586)
- nanoimmunotech (4)
- reddot Biotech (16776)
Clone Designation
- [cl0142] (1)
- [cl0143] (1)
- [cl0151] (1)
- [cl0157] (1)
- [cl0159] (1)
- [cl0160] (1)
- [cl0164] (1)
- [cl0166] (1)
- [cl0170] (1)
- [cl0171] (1)
- [cl0173] (1)
- [cl0176] (1)
- [cl0178] (1)
- [cl0182] (1)
- [cl0185] (1)
- [cl0186] (1)
- [cl0190] (1)
- [cl0197] (1)
- [cl0199] (1)
- [cl0201] (1)
- [cl0203] (1)
- [cl0206] (1)
- [cl0210] (1)
- [cl0213] (1)
- [cl0215] (1)
- [cl0216] (1)
- [cl0219] (1)
- [cl0223] (1)
- [cl0224] (1)
- [cl0225] (1)
- [cl0226] (1)
- [cl0232] (1)
- [cl0235] (1)
- [cl0236] (1)
- [cl0237] (1)
- [cl0239] (1)
- [cl0240] (1)
- [cl0241] (1)
- [cl0257] (1)
- [cl0259] (1)
- [cl0260] (1)
- [cl0262] (1)
- [cl0265] (1)
- [cl0268] (1)
- [cl0271] (1)
- [cl0273] (1)
- [cl0275] (1)
- [cl0276] (1)
- [cl0278] (1)
- [cl0280] (1)
- [cl0284] (1)
- [cl0285] (1)
- [cl0290] (1)
- [cl0296] (1)
- [cl0301] (1)
- [cl0303] (1)
- [cl0304] (1)
- [cl0305] (1)
- [cl0307] (1)
- [cl0308] (1)
- [cl0319] (1)
- [cl0320] (1)
- [cl0321] (1)
- [cl0323] (1)
- [cl0328] (1)
- [cl0331] (1)
- [cl0337] (1)
- [cl0339] (1)
- [cl0344] (1)
- [cl0345] (1)
- [cl0346] (1)
- [cl0347] (1)
- [cl0349] (1)
- [cl0351] (1)
- [cl0363] (1)
- [cl0364] (1)
- [cl0366] (1)
- [cl0368] (1)
- [cl0369] (1)
- [cl0370] (1)
- [cl0371] (1)
- [cl0374] (1)
- [cl0378] (1)
- [cl0381] (1)
- [cl0387] (1)
- [cl0395] (1)
- [cl0397] (1)
- [cl0401] (1)
- [cl0463] (1)
- [cl0465] (1)
- [cl0467] (1)
- [cl0468] (1)
- [cl0474] (1)
- [cl0485] (1)
- [cl0490] (1)
- [cl0492] (1)
- [cl0510] (1)
- [cl0524] (1)
- [cl0537] (1)
- [cl0538] (1)
- [cl0539] (1)
- [cl0542] (1)
- [cl0555] (1)
- [cl0575] (1)
- [cl0576] (1)
- [cl0580] (1)
- [cl0624] (1)
- [cl0628] (1)
- [cl0631] (1)
- [cl0639] (1)
- [cl0654] (1)
- [cl0665] (1)
- [cl0815] (1)
- [cl0822] (1)
- [cl0887] (1)
- [cl0899] (1)
- [cl10078] (1)
- [cl10130] (1)
- [cl10165] (1)
- [cl10252] (1)
- [cl10283] (1)
- [cl1028] (1)
- [cl10309] (1)
- [cl1040] (1)
- [cl10474] (1)
- [cl10543] (1)
- [cl10552] (1)
- [cl1057] (1)
- [cl10587] (1)
- [cl10591] (1)
- [cl10613] (1)
- [cl10622] (1)
- [cl10631] (1)
- [cl10632] (1)
- [cl1063] (1)
- [cl10652] (1)
- [cl10658] (1)
- [cl10662] (1)
- [cl10686] (1)
- [cl10697] (1)
- [cl10758] (1)
- [cl10765] (1)
- [cl1083] (1)
- [cl10847] (1)
- [cl10855] (1)
- [cl10884] (1)
- [cl10888] (1)
- [cl10930] (1)
- [cl10936] (1)
- [cl1095] (1)
- [cl10961] (1)
- [cl10962] (1)
- [cl10964] (1)
- [cl11023] (1)
- [cl1111] (1)
- [cl11132] (1)
- [cl1113] (1)
- [cl11142] (1)
- [cl11144] (1)
- [cl1115] (1)
- [cl11171] (1)
- [cl1118] (1)
- [cl11191] (1)
- [cl11214] (1)
- [cl11222] (1)
- [cl11225] (1)
- [cl1128] (1)
- [cl11293] (1)
- [cl11294] (1)
- [cl1129] (1)
- [cl11342] (1)
- [cl11357] (1)
- [cl11368] (1)
- [cl11380] (1)
- [cl11393] (1)
- [cl11404] (1)
- [cl11434] (1)
- [cl11463] (1)
- [cl11474] (1)
- [cl1147] (1)
- [cl11508] (1)
- [cl11547] (1)
- [cl11630] (1)
- [cl11651] (1)
- [cl11653] (1)
- [cl11661] (1)
- [cl11669] (1)
- [cl1170] (1)
- [cl11722] (1)
- [cl11723] (1)
- [cl1172] (1)
- [cl11773] (1)
- [cl1180] (1)
- [cl11865] (1)
- [cl11892] (1)
- [cl11896] (1)
- [cl11915] (1)
- [cl11945] (1)
- [cl11960] (1)
- [cl11968] (1)
- [cl1196] (1)
- [cl11981] (1)
- [cl11995] (1)
- [cl12064] (1)
- [cl12087] (1)
- [cl12090] (1)
- [cl12131] (1)
- [cl12180] (1)
- [cl12183] (1)
- [cl12185] (1)
- [cl12191] (1)
- [cl12192] (1)
- [cl12193] (1)
- [cl12241] (1)
- [cl12314] (1)
- [cl12323] (1)
- [cl12328] (1)
- [cl12334] (1)
- [cl1234] (1)
- [cl12420] (1)
- [cl12435] (1)
- [cl12448] (1)
- [cl1249] (1)
- [cl12511] (1)
- [cl12512] (1)
- [cl12514] (1)
- [cl12531] (1)
- [cl12632] (1)
- [cl12711] (1)
- [cl12732] (1)
- [cl12753] (1)
- [cl12762] (1)
- [cl12810] (1)
- [cl12822] (1)
- [cl12836] (1)
- [cl12838] (1)
- [cl12842] (1)
- [cl1284] (1)
- [cl12855] (1)
- [cl12863] (1)
- [cl12864] (1)
- [cl12874] (1)
- [cl12886] (1)
- [cl12917] (1)
- [cl12929] (1)
- [cl12954] (1)
- [cl12967] (1)
- [cl12974] (1)
- [cl12984] (1)
- [cl12988] (1)
- [cl13081] (1)
- [cl13128] (1)
- [cl13129] (1)
- [cl13130] (1)
- [cl13157] (1)
- [cl13165] (1)
- [cl13170] (1)
- [cl13176] (1)
- [cl13278] (1)
- [cl13318] (1)
- [cl13319] (1)
- [cl13324] (1)
- [cl13328] (1)
- [cl13332] (1)
- [cl13336] (1)
- [cl13358] (1)
- [cl13359] (1)
- [cl13382] (1)
- [cl1338] (1)
- [cl13403] (1)
- [cl13438] (1)
- [cl13467] (1)
- [cl1346] (1)
- [cl13472] (1)
- [cl13474] (1)
- [cl13501] (1)
- [cl13530] (1)
- [cl13563] (1)
- [cl13565] (1)
- [cl13567] (1)
- [cl13579] (1)
- [cl13589] (1)
- [cl13603] (1)
- [cl13618] (1)
- [cl13628] (1)
- [cl13683] (1)
- [cl13713] (1)
- [cl13724] (1)
- [cl13764] (1)
- [cl13779] (1)
- [cl13783] (1)
- [cl13808] (1)
- [cl13809] (1)
- [cl13814] (1)
- [cl13815] (1)
- [cl13841] (1)
- [cl13844] (1)
- [cl13859] (1)
- [cl13863] (1)
- [cl13956] (1)
- [cl13957] (1)
- [cl13965] (1)
- [cl13973] (1)
- [cl13992] (1)
- [cl14017] (1)
- [cl14031] (1)
- [cl14037] (1)
- [cl14039] (1)
- [cl14059] (1)
- [cl14064] (1)
- [cl14084] (1)
- [cl14096] (1)
- [cl14112] (1)
- [cl14114] (1)
- [cl14116] (1)
- [cl14122] (1)
- [cl14133] (1)
- [cl14164] (1)
- [cl14321] (1)
- [cl14332] (1)
- [cl14381] (1)
- [cl14436] (1)
- [cl14469] (1)
- [cl14471] (1)
- [cl14479] (1)
- [cl14486] (1)
- [cl14502] (1)
- [cl14523] (1)
- [cl14528] (1)
- [cl14531] (1)
- [cl14548] (1)
- [cl14550] (1)
- [cl14552] (1)
- [cl14556] (1)
- [cl14565] (1)
- [cl14568] (1)
- [cl14576] (1)
- [cl14579] (1)
- [cl14611] (1)
- [cl14612] (1)
- [cl14615] (1)
- [cl14617] (1)
- [cl14619] (1)
- [cl14627] (1)
- [cl1466] (1)
- [cl14693] (1)
- [cl14696] (1)
- [cl14707] (1)
- [cl14765] (1)
- [cl14773] (1)
- [cl14825] (1)
- [cl14976] (1)
- [cl1497] (1)
- [cl14991] (1)
- [cl15002] (1)
- [cl15024] (1)
- [cl15033] (1)
- [cl15043] (1)
- [cl15059] (1)
- [cl15060] (1)
- [cl15065] (1)
- [cl15070] (1)
- [cl15072] (1)
- [cl15073] (1)
- [cl15075] (1)
- [cl15076] (1)
- [cl15085] (1)
- [cl15190] (1)
- [cl15251] (1)
- [cl15257] (1)
- [cl15299] (1)
- [cl1529] (1)
- [cl15302] (1)
- [cl15308] (1)
- [cl15323] (1)
- [cl15329] (1)
- [cl15357] (1)
- [cl15364] (1)
- [cl15366] (1)
- [cl15368] (1)
- [cl15425] (1)
- [cl15426] (1)
- [cl15454] (1)
- [cl15459] (1)
- [cl15464] (1)
- [cl1546] (1)
- [cl15513] (1)
- [cl15523] (1)
- [cl15542] (1)
- [cl1555] (1)
- [cl15572] (1)
- [cl15606] (1)
- [cl15622] (1)
- [cl15628] (1)
- [cl1567] (1)
- [cl1608] (1)
- [cl1637] (1)
- [cl1638] (1)
- [cl1656] (1)
- [cl1657] (1)
- [cl1667] (1)
- [cl1673] (1)
- [cl1679] (1)
- [cl1685] (1)
- [cl1719] (1)
- [cl1831] (1)
- [cl1858] (1)
- [cl1912] (1)
- [cl1950] (1)
- [cl1957] (1)
- [cl2148] (1)
- [cl2155] (1)
- [cl2162] (1)
- [cl2199] (1)
- [cl2209] (1)
- [cl2220] (1)
- [cl2237] (1)
- [cl2240] (1)
- [cl2242] (1)
- [cl2243] (1)
- [cl2245] (1)
- [cl2287] (1)
- [cl2302] (1)
- [cl2304] (1)
- [cl2309] (1)
- [cl2310] (1)
- [cl2360] (1)
- [cl2375] (1)
- [cl2378] (1)
- [cl2384] (1)
- [cl2433] (1)
- [cl2435] (1)
- [cl2444] (1)
- [cl2446] (1)
- [cl2452] (1)
- [cl2502] (1)
- [cl2522] (1)
- [cl2524] (1)
- [cl2545] (1)
- [cl2548] (1)
- [cl2553] (1)
- [cl2561] (1)
- [cl2579] (1)
- [cl2593] (1)
- [cl2596] (1)
- [cl2603] (1)
- [cl2610] (1)
- [cl2647] (1)
- [cl2650] (1)
- [cl2660] (1)
- [cl2662] (1)
- [cl2663] (1)
- [cl2671] (1)
- [cl2678] (1)
- [cl2688] (1)
- [cl2697] (1)
- [cl2705] (1)
- [cl2713] (1)
- [cl2720] (1)
- [cl2736] (1)
- [cl2754] (1)
- [cl2782] (1)
- [cl2783] (1)
- [cl2793] (1)
- [cl2819] (1)
- [cl2827] (1)
- [cl2829] (1)
- [cl2852] (1)
- [cl2858] (1)
- [cl2871] (1)
- [cl2872] (1)
- [cl2887] (1)
- [cl2911] (1)
- [cl2914] (1)
- [cl2919] (1)
- [cl2921] (1)
- [cl2952] (1)
- [cl2962] (1)
- [cl2968] (1)
- [cl2970] (1)
- [cl2976] (1)
- [cl2979] (1)
- [cl2980] (1)
- [cl2990] (1)
- [cl2999] (1)
- [cl3004] (1)
- [cl3013] (1)
- [cl3049] (1)
- [cl3063] (1)
- [cl3087] (1)
- [cl3112] (1)
- [cl3118] (1)
- [cl3123] (1)
- [cl3169] (1)
- [cl3173] (1)
- [cl3183] (1)
- [cl3185] (1)
- [cl3195] (1)
- [cl3196] (1)
- [cl3199] (1)
- [cl3201] (1)
- [cl3202] (1)
- [cl3210] (1)
- [cl3265] (1)
- [cl3266] (1)
- [cl3299] (1)
- [cl3301] (1)
- [cl3353] (1)
- [cl3363] (1)
- [cl3392] (1)
- [cl3423] (1)
- [cl3450] (1)
- [cl3482] (1)
- [cl3484] (1)
- [cl3497] (1)
- [cl3501] (1)
- [cl3515] (1)
- [cl3524] (1)
- [cl3573] (1)
- [cl3576] (1)
- [cl3580] (1)
- [cl3595] (1)
- [cl3624] (1)
- [cl3638] (1)
- [cl3640] (1)
- [cl3689] (1)
- [cl3691] (1)
- [cl3698] (1)
- [cl3700] (1)
- [cl3708] (1)
- [cl3716] (1)
- [cl3730] (1)
- [cl3748] (1)
- [cl3760] (1)
- [cl3770] (1)
- [cl3771] (1)
- [cl3805] (1)
- [cl3807] (1)
- [cl3868] (1)
- [cl3901] (1)
- [cl3915] (1)
- [cl3929] (1)
- [cl3975] (1)
- [cl3981] (1)
- [cl3989] (1)
- [cl3991] (1)
- [cl4003] (1)
- [cl4004] (1)
- [cl4013] (1)
- [cl4035] (1)
- [cl4045] (1)
- [cl4046] (1)
- [cl4049] (1)
- [cl4164] (1)
- [cl4233] (1)
- [cl4252] (1)
- [cl4254] (1)
- [cl4265] (1)
- [cl4270] (1)
- [cl4281] (1)
- [cl4289] (1)
- [cl4290] (1)
- [cl4438] (1)
- [cl4455] (1)
- [cl4463] (1)
- [cl4472] (1)
- [cl4489] (1)
- [cl4490] (1)
- [cl4501] (1)
- [cl4502] (1)
- [cl4540] (1)
- [cl4681] (1)
- [cl4688] (1)
- [cl4716] (1)
- [cl4725] (1)
- [cl4729] (1)
- [cl4762] (1)
- [cl4844] (1)
- [cl4851] (1)
- [cl4881] (1)
- [cl4888] (1)
- [cl4906] (1)
- [cl4917] (1)
- [cl4923] (1)
- [cl4967] (1)
- [cl4968] (1)
- [cl5039] (1)
- [cl5041] (1)
- [cl5048] (1)
- [cl5101] (1)
- [cl5146] (1)
- [cl5148] (1)
- [cl5157] (1)
- [cl5245] (1)
- [cl5256] (1)
- [cl5263] (1)
- [cl5275] (1)
- [cl5278] (1)
- [cl5287] (1)
- [cl5289] (1)
- [cl5306] (1)
- [cl5310] (1)
- [cl5312] (1)
- [cl5324] (1)
- [cl5339] (1)
- [cl5346] (1)
- [cl5414] (1)
- [cl5420] (1)
- [cl5568] (1)
- [cl5634] (1)
- [cl5665] (1)
- [cl5685] (1)
- [cl5690] (1)
- [cl5692] (1)
- [cl5695] (1)
- [cl5782] (1)
- [cl5785] (1)
- [cl5803] (1)
- [cl5810] (1)
- [cl5813] (1)
- [cl5814] (1)
- [cl5817] (1)
- [cl5818] (1)
- [cl5950] (1)
- [cl6137] (1)
- [cl6228] (1)
- [cl6232] (1)
- [cl6251] (1)
- [cl6259] (1)
- [cl6313] (1)
- [cl6334] (1)
- [cl6365] (1)
- [cl6381] (1)
- [cl6426] (1)
- [cl6491] (1)
- [cl6501] (1)
- [cl6526] (1)
- [cl6528] (1)
- [cl6550] (1)
- [cl6553] (1)
- [cl6559] (1)
- [cl6607] (1)
- [cl6629] (1)
- [cl6873] (1)
- [cl6913] (1)
- [cl6915] (1)
- [cl6916] (1)
- [cl6937] (1)
- [cl6940] (1)
- [cl6945] (1)
- [cl6951] (1)
- [cl6957] (1)
- [cl6972] (1)
- [cl6973] (1)
- [cl7067] (1)
- [cl7084] (1)
- [cl7111] (1)
- [cl7207] (1)
- [cl7217] (1)
- [cl7290] (1)
- [cl7304] (1)
- [cl7318] (1)
- [cl7319] (1)
- [cl7621] (1)
- [cl7628] (1)
- [cl7716] (1)
- [cl7721] (1)
- [cl7787] (1)
- [cl7834] (1)
- [cl7899] (1)
- [cl7919] (1)
- [cl7935] (1)
- [cl7990] (1)
- [cl8102] (1)
- [cl8121] (1)
- [cl8203] (1)
- [cl8228] (1)
- [cl8266] (1)
- [cl8345] (1)
- [cl8347] (1)
- [cl8360] (1)
- [cl8472] (1)
- [cl8660] (1)
- [cl8714] (1)
- [cl8721] (1)
- [cl8723] (1)
- [cl8725] (1)
- [cl8733] (1)
- [cl8892] (1)
- [cl8961] (1)
- [cl8994] (1)
- [cl9025] (1)
- [cl9032] (1)
- [cl9071] (1)
- [cl9089] (1)
- [cl9091] (1)
- [cl9101] (1)
- [cl9148] (1)
- [cl9175] (1)
- [cl9255] (1)
- [cl9297] (1)
- [cl9360] (1)
- [cl9362] (1)
- [cl9390] (1)
- [cl9414] (1)
- [cl9422] (1)
- [cl9440] (1)
- [cl9469] (1)
- [cl9499] (1)
- [cl9500] (1)
- [cl9503] (1)
- [cl9508] (1)
- [cl9518] (1)
- [cl9662] (1)
- [cl9714] (1)
- [cl9744] (1)
- [cl9747] (1)
- [cl9766] (1)
- [cl9772] (1)
- [cl9774] (1)
- [cl9956] (1)
Anti-DDX6 Antibody , Unconjugated, Rabbit, Polyclonal
- Images: 9
- Applications: 3
| Biozol Catalog Number: | ATA-HPA024201 |
| Manufacturer: | Atlas Antibodies |
| Application: | ICC, IHC, WB |
| Category: | Antikörper |
| Size: | 100 ul, 25 ul |
| Show Prices | |









(9) Images
Anti-RABEP1 Antibody , Unconjugated, Rabbit, Polyclonal
- Images: 9
- Applications: 3
| Biozol Catalog Number: | ATA-HPA024235 |
| Manufacturer: | Atlas Antibodies |
| Application: | ICC, IHC, WB |
| Category: | Antikörper |
| Size: | 100 ul, 25 ul |
| Show Prices | |









(9) Images
Anti-SYVN1 Antibody , Unconjugated, Rabbit, Polyclonal
- Images: 9
- Applications: 1
| Biozol Catalog Number: | ATA-HPA024300 |
| Manufacturer: | Atlas Antibodies |
| Application: | IHC |
| Category: | Antikörper |
| Size: | 100 ul, 25 ul |
| Show Prices | |









(9) Images
Anti-GCN1 Antibody , Unconjugated, Rabbit, Polyclonal
- Images: 9
- Applications: 1
| Biozol Catalog Number: | ATA-HPA024367 |
| Manufacturer: | Atlas Antibodies |
| Application: | IHC |
| Category: | Antikörper |
| Size: | 100 ul, 25 ul |
| Show Prices | |

(9) Images
Anti-FHOD1 Antibody , Unconjugated, Rabbit, Polyclonal
- Images: 9
- Applications: 2
| Biozol Catalog Number: | ATA-HPA024468 |
| Manufacturer: | Atlas Antibodies |
| Application: | ICC, IHC |
| Category: | Antikörper |
| Size: | 100 ul, 25 ul |
| Show Prices | |









(9) Images
Anti-NDOR1 Antibody , Unconjugated, Rabbit, Polyclonal
- Images: 9
- Applications: 3
| Biozol Catalog Number: | ATA-HPA024504 |
| Manufacturer: | Atlas Antibodies |
| Application: | ICC, IHC, WB |
| Category: | Antikörper |
| Size: | 100 ul |
| Show Prices | |









(9) Images
Anti-FAM83H Antibody , Unconjugated, Rabbit, Polyclonal
- Images: 9
- Applications: 2
| Biozol Catalog Number: | ATA-HPA024505 |
| Manufacturer: | Atlas Antibodies |
| Application: | IHC, WB |
| Category: | Antikörper |
| Size: | 100 ul |
| Show Prices | |









(9) Images
Anti-GREB1 Antibody , Unconjugated, Rabbit, Polyclonal
- Images: 9
- Applications: 2
| Biozol Catalog Number: | ATA-HPA024616 |
| Manufacturer: | Atlas Antibodies |
| Application: | ICC, IHC |
| Category: | Antikörper |
| Size: | 100 ul, 25 ul |
| Show Prices | |









(9) Images
Anti-RPF1 Antibody , Unconjugated, Rabbit, Polyclonal
- Images: 9
- Applications: 3
| Biozol Catalog Number: | ATA-HPA024642 |
| Manufacturer: | Atlas Antibodies |
| Application: | ICC, IHC, WB |
| Category: | Antikörper |
| Size: | 100 ul, 25 ul |
| Show Prices | |









(9) Images
Anti-KIAA1456 Antibody , Unconjugated, Rabbit, Polyclonal
- Images: 9
- Applications: 2
| Biozol Catalog Number: | ATA-HPA024673 |
| Manufacturer: | Atlas Antibodies |
| Application: | ICC, IHC |
| Category: | Antikörper |
| Size: | 100 ul, 25 ul |
| Show Prices | |









(9) Images




 FIG Antibody binding in a competitive ELISA, a form of immunodetection. In this example, the target antigen has been captured on the surface of a microplate. Its presence is confirmed through the binding of an antigen-specific primary antibody, followed by the addition of a labelled secondary antibody. If the test sample were to contain the antigen, a reduction in signal would be seen since the primary antibody would bind to this and be removed from the assay during subsequent wash steps, rather than becoming attached to the microplate.
FIG Antibody binding in a competitive ELISA, a form of immunodetection. In this example, the target antigen has been captured on the surface of a microplate. Its presence is confirmed through the binding of an antigen-specific primary antibody, followed by the addition of a labelled secondary antibody. If the test sample were to contain the antigen, a reduction in signal would be seen since the primary antibody would bind to this and be removed from the assay during subsequent wash steps, rather than becoming attached to the microplate. 


